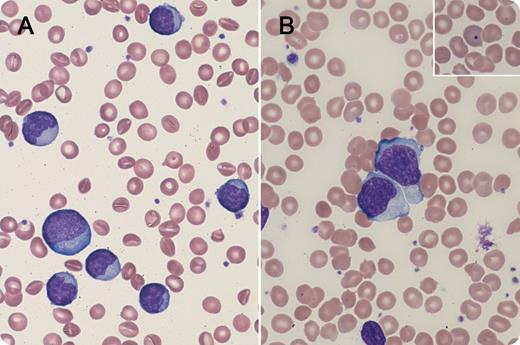
A 7-year-old boy with flu-like symptoms treated with amoxicillin presented with cervical lymphadenopathy; maculopapular rash on arms, face, and trunk; and markedly high white blood cell (WBC) count (100 × 109/L) and high absolute lymphocyte count (85 × 109/L). The peripheral smear revealed a heterogeneous population of lymphocytes (panels A and B). Howell-Jolly bodies were also seen (panel B inset) consistent with his therapeutic splenectomy for hereditary spherocytosis. A monospot (heterophile) test was positive, and serum immunoglobulin M antibody to viral capsid antigen was elevated. Quantitative polymerase chain reaction for Epstein-Barr virus (EBV) was 19 360 copies/mL. Flow cytometry revealed a polyclonal population of T-lymphocytes (85% CD3+, 11% CD3/4+, 70% CD3/8+). Molecular studies showed T-cell receptor β and γ gene clonal rearrangements. The patient was treated supportively and improved clinically. The WBC count decreased to 13.9 × 109/L (Abs lymph: 8.8 × 109/L) over the next several weeks. / This case of infectious mononucleosis is highly unusual in that extreme leukocytosis is rarely associated with reactive conditions. Although clonal rearrangements of the T-cell receptor genes were positive, they were most likely secondary to EBV infection. The peripheral smear morphology demonstrated a reactive proliferation of lymphocytes consistent with EBV infection. Classic clinical findings were also exhibited including a morbilliform rash that developed after empiric ampicillin.

A 7-year-old boy with flu-like symptoms treated with amoxicillin presented with cervical lymphadenopathy; maculopapular rash on arms, face, and trunk; and markedly high white blood cell (WBC) count (100 × 109/L) and high absolute lymphocyte count (85 × 109/L). The peripheral smear revealed a heterogeneous population of lymphocytes (panels A and B). Howell-Jolly bodies were also seen (panel B inset) consistent with his therapeutic splenectomy for hereditary spherocytosis. A monospot (heterophile) test was positive, and serum immunoglobulin M antibody to viral capsid antigen was elevated. Quantitative polymerase chain reaction for Epstein-Barr virus (EBV) was 19 360 copies/mL. Flow cytometry revealed a polyclonal population of T-lymphocytes (85% CD3+, 11% CD3/4+, 70% CD3/8+). Molecular studies showed T-cell receptor β and γ gene clonal rearrangements. The patient was treated supportively and improved clinically. The WBC count decreased to 13.9 × 109/L (Abs lymph: 8.8 × 109/L) over the next several weeks.
This case of infectious mononucleosis is highly unusual in that extreme leukocytosis is rarely associated with reactive conditions. Although clonal rearrangements of the T-cell receptor genes were positive, they were most likely secondary to EBV infection. The peripheral smear morphology demonstrated a reactive proliferation of lymphocytes consistent with EBV infection. Classic clinical findings were also exhibited including a morbilliform rash that developed after empiric ampicillin.
A 7-year-old boy with flu-like symptoms treated with amoxicillin presented with cervical lymphadenopathy; maculopapular rash on arms, face, and trunk; and markedly high white blood cell (WBC) count (100 × 109/L) and high absolute lymphocyte count (85 × 109/L). The peripheral smear revealed a heterogeneous population of lymphocytes (panels A and B). Howell-Jolly bodies were also seen (panel B inset) consistent with his therapeutic splenectomy for hereditary spherocytosis. A monospot (heterophile) test was positive, and serum immunoglobulin M antibody to viral capsid antigen was elevated. Quantitative polymerase chain reaction for Epstein-Barr virus (EBV) was 19 360 copies/mL. Flow cytometry revealed a polyclonal population of T-lymphocytes (85% CD3+, 11% CD3/4+, 70% CD3/8+). Molecular studies showed T-cell receptor β and γ gene clonal rearrangements. The patient was treated supportively and improved clinically. The WBC count decreased to 13.9 × 109/L (Abs lymph: 8.8 × 109/L) over the next several weeks.
This case of infectious mononucleosis is highly unusual in that extreme leukocytosis is rarely associated with reactive conditions. Although clonal rearrangements of the T-cell receptor genes were positive, they were most likely secondary to EBV infection. The peripheral smear morphology demonstrated a reactive proliferation of lymphocytes consistent with EBV infection. Classic clinical findings were also exhibited including a morbilliform rash that developed after empiric ampicillin.
For additional images, visit the ASH IMAGE BANK, a reference and teaching tool that is continually updated with new atlas and case study images. For more information visit http://imagebank.hematology.org.

This feature is available to Subscribers Only
Sign In or Create an Account Close Modal